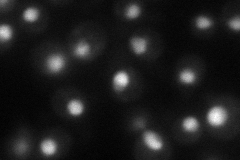
YJL127C
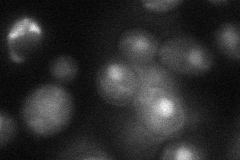
YJL127C
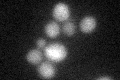
YJL127C
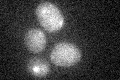
YJL127C

View description
Putative histone acetylase, sequence-specific activator of histone genes, binds specifically and highly cooperatively to pairs of UAS elements in core histone promoters, functions at or near the TATA box
Localization:
Intensity:
Fold change:
Significance:
-
C’ GFP library in SD

below threshold15.13 -
N' NOP1pr-GFP in SD
nucleus56.0033 -
N' TEF2pr-mCherry in SD

nucleus37.8773 -
N' NATIVEpr-GFP in SD

nucleus22.488 -
N' TEF2pr-VC and Cyto-VN in SD
nucleus40.1348 -
C’ GFP library in SD+DTT
cytosol16.651.1No -
C’ GFP library in SD+H2O2

cytosol18.191.2No -
C’ GFP library in Starvation Media
cytosol17.441.15No -
C’ GFP library on the background of Pup2-DaMP

below threshold -
C’ GFP library on the background of CCT mutant

below threshold16.93021.11853No
